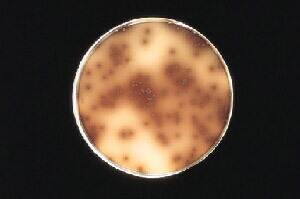
李斯特菌落

-
李斯特菌 编辑
李斯特菌(学名:Listeria monocytogenes),又名单核球增多性李斯特菌、李氏菌,是一种兼性厌氧细菌,为李斯特菌病的病原体。李斯特菌是革兰氏阳性菌,属厚壁菌门,取名自约瑟夫·李斯特。它主要以食物为传染媒介,是最致命的食源性病原体之一 。
李斯特菌在环境中无处不在,在绝大多数食品中都能找到李斯特菌。肉类、蛋类、禽类、海产品、乳制品、蔬菜等都已被证实是李斯特菌的感染源。李斯特菌中毒严重的可引起血液和脑组织感染,很多国家都已经采取措施来控制食品中的李斯特菌,并制定了相应的标准。
2019年10月7日,德国联邦消费者保护与食品安全局宣布召回逾千种肉类商品。原因是其可能被李斯特菌污染。 2024年,美国多州报告李斯特菌感染病例,造成2人死亡,20余人住院。
中文名:李斯特菌
界:细菌界
门:厚壁菌门
纲:芽孢杆菌纲
目:芽孢杆菌目
属:李斯特菌属
分布区域:世界各地
国际上公认的李斯特菌共有十个菌株:
1.单核细胞增生李斯特菌(L.monocytogenes)
2.绵羊李斯特菌 (L.iuanuii)
3.英诺克李斯特菌(L.innocua)
4.威尔斯李斯特菌(L.welshimeri)
5.西尔李斯特菌 (L.seeligeri)
6.格氏李斯特菌(L.grayi)
7.默氏李斯特菌 (L.murrayi)(存疑,WHO以及The Prokaryotes(Rosenberg, Eugene & DeLong, Edward F.)中10个species里有L. marthii 而没有L. murrayi)
8. L. rocourtiae
9. L. fleischmannii
10. L. weihenstephanensis
其中根据16S rRNA序列,L. grayi已经从genus Listeria中分离出去,属于genus murraya。
其中单增李斯特菌是唯一能引起人类疾病的。单核增生李斯特菌(Listeria monocytogenes)是一种常见的土壤细菌,在土壤中它是一种腐生菌,以死亡的和正在腐烂的有机物为食。它也是某些食物(主要是鲜奶产品)中的一种污染物,能引起严重食物中毒。单核细胞增生李斯特氏菌是一种人畜共患病的病原菌。它能引起人、畜的李氏特菌病,感染后主要表现为败血症、脑膜炎和单核细胞增多。它广泛存在于自然界中,食品中存在的单增李氏菌对人类的安全具有危险,该菌在4℃的环境中仍可生长繁殖,是冷藏食品威胁人类健康的主要病原菌之一。关于在一系列不同生长条件下单核增生李斯特菌转录组(细胞中的全部mRNA转录体)的一项新的研究,搞清了从腐生到致病生活方式的这种转变的性质。该研究的数据显示了一个转录程序,其复杂程度出乎意料,它涉及50个非编码RNA,同时还有一系列新的调控RNA,包括几个长反义RNA。在感染过程中,李斯特菌通过协调的全组转录变化成功重塑其转录程序,其中某些非编码RNA优先在小肠或血液中生长的细胞中表达。
特点
1.分布广:存在于土壤、水域(地表水、污水、废水)、昆虫、植物、蔬菜、鱼、鸟、野生动物、家禽。
2.生存环境可塑性大:能在2-42℃下生存(也有报道0℃能缓慢生长)能在冰箱冷藏室内较长时间生长繁殖。
3.适应范围大:酸性、碱性条件下都适应。
4.带菌较高的食品有:牛奶和乳制品;肉类(特别是牛肉);蔬菜;沙拉;海产品;冰淇凌等。
李斯特氏菌广泛分布在自然界中,在腐烂的植物、土壤、动物粪便、污水、青贮饲料和水中均可找到其踪迹。总体上说,李斯特氏菌可能存在于有乳酸菌、索丝菌和一些棒状杆菌生活的地方。它们和奶制品、青贮饲料的关系,与乳酸菌与这些产品的关系一样,是众所周知的。在苏格兰进行的一项针对海鸥粪便、白嘴鸦和青贮饲料的研究中发现,在污水处理场觅食的海鸥携带李斯特氏菌的比例比其他地方要高,白嘴鸦粪便样品中通常含有少量的李斯特氏菌。单核细胞增生李斯特氏菌和英诺克李斯特氏菌是经常发现的菌种,而西尔李斯特氏菌仅在一份样品中被发现。在这个研究中,44%的发霉的青贮饲料和22.2%的大捆的青贮饲料中发现了单核细胞增生李斯特氏菌和英诺克李斯特氏菌。在丹麦,75个青贮饲料样品中的15%呈单核细胞增生李斯特氏菌阳性,75个母牛的粪便样品中52%含该菌。在pH值高于和低于4.5的青贮饲料中均发现单核细胞增生李斯特氏菌。在麦地、牧场、淤泥、动物粪便、野生动物饲养场及其他相关来源的8.4%~44%的样品中分离到了此菌。已经证实单核细胞增生李斯特氏菌可以在潮湿土壤中存活295天甚至更长。在对加利福尼亚沿海水域的研究中,37个淡水或者低盐水样品中的62%与46个淤泥样品中的17.4%呈阳性,而在35个牡蛎样品中没有培养出单核细胞增生李斯特氏菌 。
流行情况
1999年底,美国发生了历史上因食用带有李斯特菌的食品而引发的最严重的食物中毒事件,据美国疾病控制和防治中心资料显示,在美国密歇根州有14人因食用被该菌污染的“热狗”和熟肉而死亡,在另外22个州97人患此病,6名妇女流产。
1992-1995年法国出产的奶酪及猪肉中发现李斯特菌,2001年11月以来,我国质检部门多次从美国、加拿大、法国、爱尔兰、比利时、丹麦等二十多家肉类加工厂进口的猪腰、猪肚、猪耳、小排等三十多批近千吨猪副产品中检出单增李斯特菌、沙门氏菌等致病菌。
美国疾控中心2011年9月28日说,美国已有18个州72人因食用受李斯特菌污染的甜瓜而染病.美国《侨报》报道 李斯特菌已致全美16人死亡。这是美国自1998年以来致死人数最多的一次食源性疾病疫情。 李斯特菌潜伏期长,从食用受污染食品至发病,一般间隔1至8周,因此疾控中心估计,随着10月份更多李斯特菌感染者的症状开始明显,确诊病例将持续增多。
李斯特菌比常见的沙门氏菌和某些大肠杆菌更为致命。美国上次暴发李斯特菌大规模感染是在1998年,21人因食用受这种病菌感染的热狗等肉类熟食死亡。1985年,52人死于食用受这种病菌感染的软干酪。
经调查,位于科罗拉多州的延森农场是这次大规模感染李斯特菌事件的源头。这家农场从9月14日起宣布召回其生产的“罗基·福特”牌香瓜。不过,目前仍不清楚李斯特菌是如何污染这种水果的。美国食品和药物管理局局长马格丽特·汉伯格说,这是首次发现李斯特菌能进入完整的甜瓜内部,该局正努力寻找其原因。延森农场说他们向美国25个州销售了该品牌的香瓜,但食品和药物管理局认为区域可能更广,因为疫情爆发地已经超过了这家农场的销售清单。延森农场说,他们销售了超过30万盒问题香瓜,每盒5至15个,因而香瓜召回总数在150到450万个之间。
疾控中心主任弗里登说,尽管受污染的香瓜已经下架,这种病菌仍可能“作乱”,因为它生命力强,能在低温环境甚至冰箱内存活。
李斯特菌通常在过期速食、黄油、冻肉和奶酪上蔓延滋长。食品和药物管理局说,全美每年有大约800例李斯特菌染病病例,大多数因为食用上述食品,农产品一般不是使人染病的元凶。老年人、孕妇和慢性病患者等免疫力较差人群最易感染李斯特菌。疾控中心说,13名死者多是年长者,平均年龄为78岁。
据悉,一旦感染李斯特菌,轻则出现发烧、肌肉疼痛、恶心、腹泻等症状,重则出现头痛、颈部僵硬、身体失衡和痉挛等症状。受感染的孕妇可能出现早产、流产和死产,婴儿健康也可能受影响。
李斯特菌落
李斯特菌落
该菌可通过眼及破损皮肤、粘膜进入体内而造成感染,孕妇感染后通过胎盘或产道感染胎儿或新生儿,栖居于阴道、子宫颈的该菌也引起感染,性接触也是本病传播的可能途径,且有上升趋势。
季节性特点:春季可发生,而发病率在夏、秋季呈季节性增长。
食品种类:主要食品有乳及乳制品、肉制品、水产品蔬菜及水果。
食品中李斯特菌的污染来源和中毒的原因:
牛乳中李斯特菌的污染主要来自粪便;由于肉尸在屠宰过程易污染,在销售过程中,食品从业人员的手也可造成污染。由于该菌能在冷藏条件下生长繁殖,故用冰箱冷藏食品,不能抑制它的繁殖。该菌重度主要为大量李斯特菌的活菌侵入肠道所致;此外也与李斯特菌溶血素O有关 。
单增李斯特菌进入人体是否得病与菌量和宿主的年龄免疫状态有关,因为该菌是一种细胞内寄生菌,宿主对它的清除主要靠细胞免疫功能,因此,易感者为新生儿、孕妇、40岁以上的成人,免疫功能缺陷者。
潜伏期
在感染后3-70天出现症状,健康成人可出现轻微类似流感症状,易感者突然发热,剧烈头痛、恶心、呕吐、腹泻、败血症、脑膜炎、孕妇出现流产。
单增李氏菌的抗原结构与毒力无关,它的致病性与毒力机理如下:
1.寄生物介导的细胞内增生,使它附着及进入肠细胞与巨噬细胞。
2.抗活化的巨噬细胞,单增李氏菌有细菌性过氧化物歧化酶,使它能抗活化巨噬细胞内的过氧物(为杀菌的毒性游离基团)分解。
3.溶血素,即李斯特杆菌溶血素O,可以从培养物上清液中获得,为SH活化的细胞溶素,有α和β两种,为毒力因子。
临床表现
健康成人个体出现轻微类似流感症状,新生儿、孕妇、免疫缺陷患者表现为呼吸急促、呕吐、出血性皮疹、化脓性结膜炎、发热、抽搐、昏迷、自然流产、脑膜炎、败血症直至死亡。
控制
单增李斯特氏菌在一般热加工处理中能存活,热处理已杀灭了竞争性细菌群,使单增李斯特氏菌在没有竞争的环境条件下易于存活,所以在食品加工中,中心温度必须达到70℃持续2分钟以上。单增李斯特氏菌在自然界中广泛存在,所以即使产品已经过热加工处理充分灭活了单增李斯特氏菌,但有可能造成产品的二次污染,因此蒸煮后防止二次污染是极为重要的。由于单增李斯特氏菌在4℃下仍然能生长繁殖,所以未加热的冰箱食品增加了食物中毒的危险。冰箱食品需加热后再食用,如果是生鱼片之类的海鲜,专业酒店都会存放于零下40摄氏度左右的大型冰柜,以确保杀灭寄生虫及防止病菌感染。
2019年10月7日,德国联邦消费者保护与食品安全局宣布召回逾千种肉类商品。原因是其可能被李斯特菌污染。其网站上发布逾千种召回商品的目录,其中包括香肠、比萨饼和面包等种类。德国多家大型连锁超市已经下架相关商品。
2022年2月1日,根据美国疾控中心的报告,新鲜蔬果供应商都乐加工生产的袋装蔬菜沙拉感染李斯特菌,截至目前已导致美国13个州的17人患病,2人死亡。
2022年6月30日,据美联社报道,美国疾控中心(CDC)卫生官员当天表示,美国新一波李斯特菌感染事件已导致23人患病,1人死亡。
2022年11月10日,美国疾病控制与预防中心宣布,发现李斯特菌疫情已导致16人感染,至少13人住院,1名孕妇因感染李斯特菌流产,马里兰州报告了1人死亡。
当地时间2022年11月10日,据美国广播公司(ABC)报道,美国疾病控制和预防中心(CDC)宣布,将对在6个不同州报告的李斯特菌感染展开调查。
2023年11月20日,美国疾病控制和预防中心发布公告说,截至11月17日,美国已有7个州报告了11例李斯特菌感染病例,其中10人入院治疗,1人死亡。
当地时间2024年7月19日,美国疾病控制和预防中心(CDC)表示,美国多州报告李斯特菌感染病例,造成2人死亡,20余人住院。
当地时间2024年8月28日,美国疾病控制与预防中心(CDC)表示,与熟食肉类有关的李斯特菌感染又导致14例新病例,以及6人死亡。使得本轮李斯特菌感染病例的总数达到57例,所有病例都需住院治疗,总共有9人死亡。
美国每年有大约800例李斯特菌染病病例,大多数因为食用上述食品。李斯特菌生命力强,能在低温环境甚至冰箱中存活。一旦发现家中有受污染的香瓜,应立即扔掉,清理并消毒那些存放它们的区域。单增李斯特菌在4℃冰箱保存的食品中也能生长繁殖,人们在未经高温彻底加热处理的情况下食用,就会出现感染症状,因而李斯特菌病又称为“冰箱病”。
李斯特菌高温即可灭掉。个人平时及家庭的具体预防措施包括:
1.尽量避免生吃鱼肉、牛肉、蔬菜,禁食腐烂变质的食品,生食瓜果应洗净,冰箱食品的储存应生熟食分开。
2.冰箱存放的食品食用前应高温充分加热,温度必须达到70℃持续两分钟以上。放进冰箱的食品一定要新鲜。
3.孕妇与免疫能力低下的人,应避免食用未经消毒的牛奶、软奶酪和未经煮熟的蔬菜,食物应彻底煮熟后再食用。
1、本站所有文本、信息、视频文件等,仅代表本站观点或作者本人观点,请网友谨慎参考使用。
2、本站信息均为作者提供和网友推荐收集整理而来,仅供学习和研究使用。
3、对任何由于使用本站内容而引起的诉讼、纠纷,本站不承担任何责任。
4、如有侵犯你版权的,请来信(邮箱:baike52199@gmail.com)指出,核实后,本站将立即删除。






























